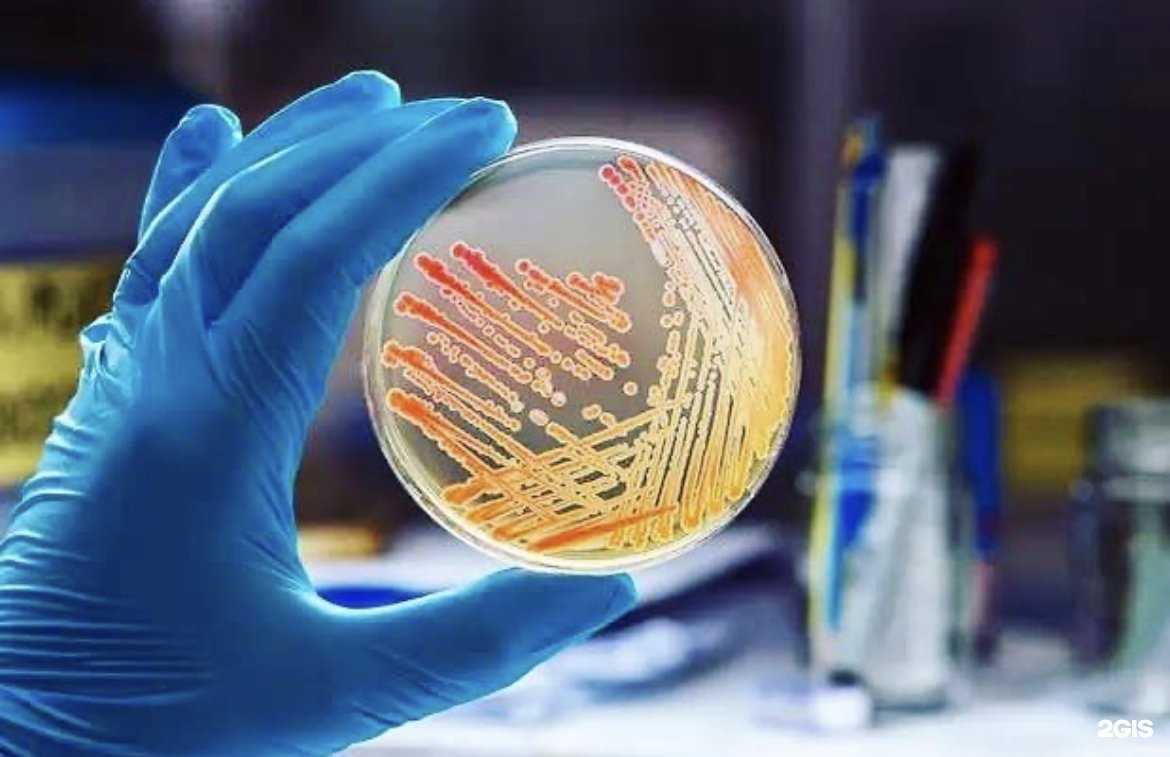
Отзывы на компанию Федеральный центр оценки безопасности и качества продукции агропромышленного комплекса в Ставрополе c фото

Описание
Северо-Кавказский филиал
Северо-Кавказский филиал

Ставрополь, Старомарьевское шоссе, 34
+7 (865) 228-00-44
Обслуживание было на высоком уровне. Помощь оказали быстро и профессионально, сотрудники работают…
Замечательный магазин, советую!
Я договорилась на осмотр салона красоты, технический специалист приехал на следующий день,…
Отличный сервис! Обратился с проблемой — при прогретом двигателе обороты колебались. Быстро провели…
Эта шаурма просто потрясающая, посетители приходят группами и заказывают по десятку штук. Повар…
Прекрасный сервис. Передавал свой Пассат с DSG-7 на ремонт, и все было сделано профессионально и…
Отличный вариант для приобретения строительных материалов. Большой ассортимент товаров и…
Здравствуйте! Уже много лет приобретаю аккумуляторы у вас, и за всё время ни одного дефекта.…
Отличный ассортимент и доступные цены.
Это самые вкусные роллы в городе, доставка очень быстрая. Всё всегда свежее, особенно запечённые…
Откройте для себя интересные места, основываясь на отзывах других пользователей и рейтингах.
Ваша звявка принята.
Вы успешно авторизовались
Вы успешно зарегистрировались
Вы завершили сессию
Ваш отзыв отправлен на модерацию
Компания отправлена на модерацию.
Модерация может занять несколько дней.
Прекрасная организация.
Этот отзыв отражает субъективное мнение пользователя, а не официальную позицию данного ресурса. Мы проверяем отзывы.
Отличная компания, очень довольен(а) сотрудничеством.
Этот отзыв отражает субъективное мнение пользователя, а не официальную позицию данного ресурса. Мы проверяем отзывы.